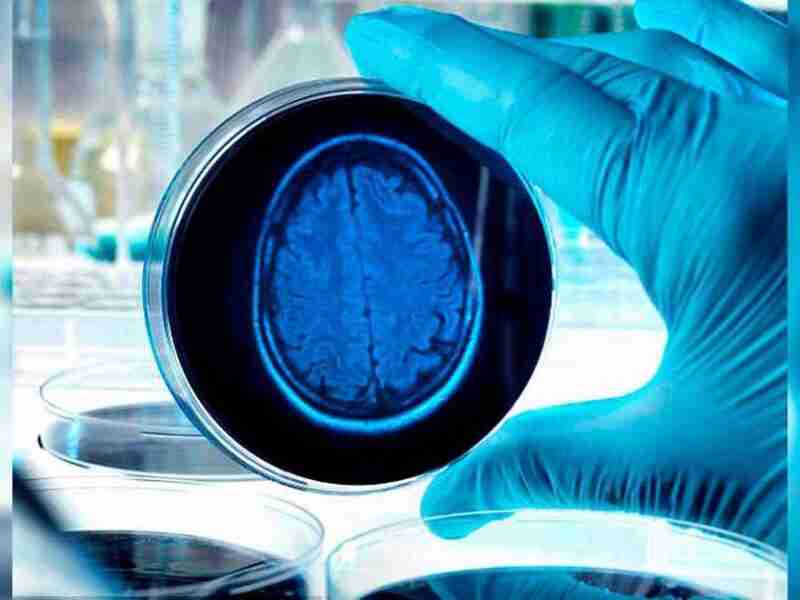

Ahora puedes leer el artículo de La Voz del Muro sobre Un mero encefalograma podría servir para diagnosticar precozmente el Alzheimer.
En la actualidad, 30 millones de personas de todo el mundo padecen Alzheimer. Sin embargo, las estimaciones de la Organización Mundial de la Salud (OMS) en cuanto a la cifra global de afectados en 3 décadas es aún más preocupante, ya que ascenderá hasta los 53 millones.
Y es que, a pesar de…